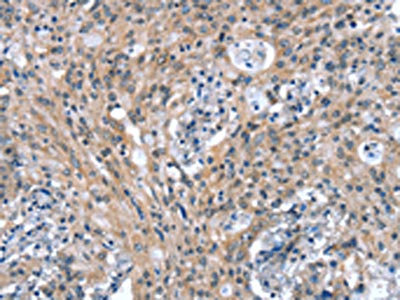

CTBP1 Antibody
-
中文名稱:CTBP1兔多克隆抗體
-
貨號:CSB-PA783700
-
規(guī)格:¥1100
-
圖片:
-
The image on the left is immunohistochemistry of paraffin-embedded Human gastic cancer tissue using CSB-PA783700(CTBP1 Antibody) at dilution 1/25, on the right is treated with synthetic peptide. (Original magnification: ×200)
-
The image on the left is immunohistochemistry of paraffin-embedded Human thyroid cancer tissue using CSB-PA783700(CTBP1 Antibody) at dilution 1/25, on the right is treated with synthetic peptide. (Original magnification: ×200)
-
Gel: 8%SDS-PAGE, Lysate: 40 μg, Lane: Mouse brain tissue, Primary antibody: CSB-PA783700(CTBP1 Antibody) at dilution 1/400, Secondary antibody: Goat anti rabbit IgG at 1/8000 dilution, Exposure time: 10 minutes
-
-
其他:
產(chǎn)品詳情
-
Uniprot No.:
-
基因名:
-
別名:BARS antibody; brefeldin A- ribosylated substrate antibody; C terminal binding protein 1 antibody; C-terminal-binding protein 1 antibody; CTBP antibody; CtBP1 antibody; CTBP1_HUMAN antibody; MGC104684 antibody
-
宿主:Rabbit
-
反應(yīng)種屬:Human,Mouse,Rat
-
免疫原:Synthetic peptide of Human CTBP1
-
免疫原種屬:Homo sapiens (Human)
-
標(biāo)記方式:Non-conjugated
-
抗體亞型:IgG
-
純化方式:Antigen affinity purification
-
濃度:It differs from different batches. Please contact us to confirm it.
-
保存緩沖液:-20°C, pH7.4 PBS, 0.05% NaN3, 40% Glycerol
-
產(chǎn)品提供形式:Liquid
-
應(yīng)用范圍:ELISA,WB,IHC
-
推薦稀釋比:
Application Recommended Dilution ELISA 1:1000-1:2000 WB 1:200-1:1000 IHC 1:25-1:100 -
Protocols:
-
儲存條件:Upon receipt, store at -20°C or -80°C. Avoid repeated freeze.
-
貨期:Basically, we can dispatch the products out in 1-3 working days after receiving your orders. Delivery time maybe differs from different purchasing way or location, please kindly consult your local distributors for specific delivery time.
-
用途:For Research Use Only. Not for use in diagnostic or therapeutic procedures.
相關(guān)產(chǎn)品
靶點詳情
-
功能:Corepressor targeting diverse transcription regulators such as GLIS2 or BCL6. Has dehydrogenase activity. Involved in controlling the equilibrium between tubular and stacked structures in the Golgi complex. Functions in brown adipose tissue (BAT) differentiation.
-
基因功能參考文獻:
- F-box only protein 32 (FBXO32) directly ubiquitinates C-terminal binding protein 1 (CtBP1), which is required for its stability and nuclear retention. PMID: 29142217
- As part of a complex including PI4KIIIbeta, a 14-3-3gamma dimer, as well as to ARF and the PKD and PAK kinases, BARS binds to and activates a trans-Golgi lysophosphatidic acid (LPA) acyltransferase type delta (LPAATdelta) that converts LPA into phosphatidic acid (PA); and that this reaction is essential for fission of post-Golgi transport carriers. PMID: 27401954
- through targeting CtBP1-mediated suppression of the Epithelial-mesenchymal transition process, miR-644a might suppress the tumor metastasis of gastric cancer cells PMID: 27983935
- Overall, our findings reveal that CtBP1/2 is essential to promote to human glioma cell growth through maintaining the DNA stability regulated by the MRN/ATR/Chk1/CDK2/HIF-1alpha signaling pathway. PMID: 27699603
- A review of CtBP structure, role in tumor progression, and discovery and development of CtBP inhibitors that target CtBP's dehydrogenase activity and other functions, with a focus on the theory and rationale behind the designs of current inhibitors. [review] PMID: 28532298
- miR-644a/CTBP1/p53 have roles in suppressing breast cancer drug resistance by inhibiting cell survival and epithelial-mesenchymal transition PMID: 27409664
- Study reports a recurrent de novo C-terminal binding protein 1 (CTBP1) mutation is associated with developmental delay, hypotonia, ataxia, and tooth enamel defects. This is the first report of mutations within CTBP1 in association with any human disease. PMID: 27094857
- Pinin and CtBP1 and CtBP2 are oncotargets that closely interact with each other to regulate transcription and pre-mRNA alternative splicing and promote cell adhesion and other epithelial characteristics of ovarian cancer cells. PMID: 26871283
- the importance of the oligomeric state of CtBP for coactivation of NeuroD1-dependent transcription, was investigated. PMID: 27880001
- C-terminal binding protein 1 is a critical factor linking changes in cell metabolism to cell phenotype in hypoxic and other forms of pulmonary hypertension PMID: 27562971
- CtBP1 increased breast tumor growth in MeS mice modulating multiple genes and miRNA expression implicated in cell proliferation, progenitor cells phenotype, epithelial to mesenchymal transition, mammary development and cell communication in the xenografts. PMID: 26933806
- These data uncovered that CtBP1 protein is a valuable marker of glioma pathogenic process and that CtBP1 can serve as a novel prognostic marker for glioma therapy. PMID: 27160109
- human chorionic gonadotropin stimulated miR-212, which down-regulated OLFM1 and CTBP1 expression in fallopian and endometrial epithelial cells to favor spheroid attachment PMID: 26377223
- It is a putative target gene of miR-137 in breast neoplasms. PMID: 26337822
- CtBP physically interacted with TCF-4, and this interaction was significantly inhibited in the presence of MTOB. The above findings point to a novel role of CtBPs in the promotion of CSC growth and self-renewal PMID: 25483087
- High CtBP1 expression is associated with Prostate tumor. PMID: 24842953
- C-terminal-binding protein (CtBP) was found to have an essential role in promoting glutaminolysis by directly repressing the expression of SIRT4. PMID: 25633289
- MCRIP1, an ERK substrate, mediates ERK-induced gene silencing during epithelial-mesenchymal transition by regulating the co-repressor CtBP. PMID: 25728771
- Transactivation of Ctbp was dependent on the histone H3 lysine 9 (H3K9) demethylase activity of LSD1 facilitates subsequent H3K9 acetylation by the NeuroD1-associated histone acetyltransferase, P300/CBP-associated factor. PMID: 24732800
- Crystal structures of human CtBP1 and CtBP2 in complex with 4-Methylthio 2-oxobutyric acid and NAD. PMID: 24657618
- A transgenic model suggests transcriptional activities of CtBP1 for epithelial mesenchymal interplay and a possibility of a pathogenic role in hair follicle morphogenesis and differentiation. PMID: 24280726
- CtBP1 was upregulated in HCC. PMID: 23756565
- High CTBP1 expression is associated with gastric cancer. PMID: 23907728
- dinucleotide binding permits CtBP1 to form an intranuclear homodimer through a Trp(318) switch, creating a nucleation site for multimerization through the C-terminal domain for tetramerization to form an effective repression complex PMID: 23940047
- Interaction of E1A with importin alpha3/Qip1, dual-specificity tyrosine-regulated kinase 1A (DYRK1A), HAN11, and CtBP influenced transformation with E1B-55K. PMID: 23864635
- Authors found that PLEIAD also interacts with CTBP1 (C-terminal binding protein 1), a transcriptional co-regulator, and CTBP1 is proteolyzed in COS7 cells expressing CAPN3. PMID: 23707407
- Interaction with CtBP suppresses the immortalization activity of adenovirus E1A in primary epithelial cells and is needed for efficient virus replication during productive infecction. PMID: 23747199
- Data show that ADP-ribosylation of CtBP1-S/BARS by brefeldin A (BFA) occurs via synthesis of a BFA-ADP-ribose conjugate by the ADP-ribosyl cyclase CD38 and covalent binding of the BFA-ADP-ribose conjugate into the CtBP1-S/BARS NAD(+)-binding pocket. PMID: 23716697
- These findings provide connections of AMPK with CtBP1-mediated regulation of Bax expression for cell death under metabolic stresses. PMID: 23291169
- CtBP1 is expressed in melanoma and represses the transcription of p16INK4a and Brca1. PMID: 23303449
- These findings define broad roles for CtBP in breast cancer biology. PMID: 23385593
- High CtBP1 expression is associated with prostate cancer progression. PMID: 23097625
- CtBP is expressed in adenohypophyseal cells and is expressed at high levels in human corticotroph, somatotroph, and lactotroph pituitary adenomas PMID: 22301782
- CtBP1 down-regulates Brca1 and E-cadherin genes in human breast cancer. PMID: 21681822
- CtBP1 and CtBP2 promote the oligomerization of truncated APC through binding to the 15 amino acid repeats of truncated APC. PMID: 21665989
- In breast tumours, both major CTBP1 mRNA splice forms are variably expressed. PMID: 20964627
- CtBP1 represses Brca1 transcription by binding to the E2F4 site of the Brca1 promoter. The recruitment of CtBP1 to the Brca1 promoter increased at high NADH levels in hypoxic conditions. PMID: 20818429
- The Tel-CtBP complex conditions endothelial cells for angiogenesis by controlling the balance between stimulatory and antagonistic sprouting cues. PMID: 20835243
- this study reveals a novel combinatorial role for Bcl3 and CtBP1, providing an explanation for the acquisition of resistance to apoptosis in cancer cells, which is a major requirement for cancer development. PMID: 20800578
- Co-expression of Pc2 and Akt1 results in both phosphorylation and ubiquitylation of CtBP1, thereby targeting CtBP1 for degradation. PMID: 20361981
- CtBP proteins repress transcription in a histone deacetylase dependent or independent manner. PMID: 11864595
- Interaction with CtBP was shown to be important in the repression of transcription by EBNA3A and in the ability of EBNA3A to immortalize and transform primary cells PMID: 12372828
- biochemical and crystallographic studies reveal that CtBP, a transcription corepressor, is a functional NAD(+)-regulated dehydrogenase. PMID: 12419229
- CtBP co-repressor complex mediates coordinated histone modifications PMID: 12700765
- The corepressor C-terminal-binding protein binds the MLL repression domain. PMID: 12829790
- Smad6 repressed bone morphogenetic protein-induced Id1 transcription through recruiting transcriptional corepressor C-terminal binding protein (CtBP). PMID: 14645520
- the interaction of Pnn with the corepressor CtBP1 may modulate repression of E-cadherin transcription by CtBP1 PMID: 15542832
- AML1-FOG2 and FOG2-AML1 are expressed in myelodysplastic syndrome; results suggest a central role for CtBP in AML1-FOG2 transcriptional repression and implicate coordinated disruption of AML1 and GATA developmental programs in the disease pathogenesis PMID: 15705784
- Homeodomain-interacting protein kinase-2 (HIPK2) mediates CtBP phosphorylation and degradation in UV-triggered apoptosis. PMID: 15708980
- results lead to conclusion that, in colon epithelial cells, the expression level of the K18 gene is kept in check by a repression mechanism involving CtBP1, HDAC & BRCA1; mechanism is altered in SW613-S colon carcinoma cells that overexpress the K18 gene PMID: 15831101
顯示更多
收起更多
-
亞細(xì)胞定位:Cytoplasm. Nucleus.
-
蛋白家族:D-isomer specific 2-hydroxyacid dehydrogenase family
-
組織特異性:Expressed in germinal center B-cells.
-
數(shù)據(jù)庫鏈接:
Most popular with customers
-
-
YWHAB Recombinant Monoclonal Antibody
Applications: ELISA, WB, IHC, IF, FC
Species Reactivity: Human, Mouse, Rat
-
Phospho-YAP1 (S127) Recombinant Monoclonal Antibody
Applications: ELISA, WB, IHC
Species Reactivity: Human
-
-
-
-
-